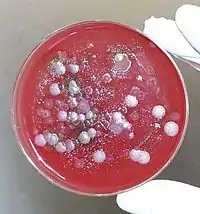

Біологічні агенти
Біологі́чні аге́нти — збудники інфекційних хвороб або токсини, що можуть використовуватися як біологічна зброя або засоби біотероризму. Відомо близько 1200 типів біологічних агентів, але не всіх їх включено до переліку офіційно визнаних чинників біологічної зброї.[1][2].
Біологічні агенти можуть включати вірусів, бактерій, патогенних мікросопічних грибів, найпростіших) та деяких багатоклітинних еукаріотів (зокрема паразити), так саме як і асоційовані з ними, так і не асоційовані токсини. Біологічні агенти мають здібність негативно впливати на здоров'я людини, спричинюючи від алергічної реакції до значно серйозніших проблем, включаючи смерть. Ці організми зазвичай поширені в навколишньому середовищі та вибрані за тими критеріями, що вони швидко розмножуються, вимагають невеликих витрат на зберігання та можуть бути передані багатьма шляхами передачі інфекції.
Примітки
- Приложение 3 Биологические и химические агенты//Руководство ВОЗ «Ответные меры системы общественного здравоохранения на угрозу применения биологического и химического оружия» (рос.)
- Список товарів подвійного використання, що можуть бути використані у створенні бактеріологічної (біологічної) та токсинної зброї, затверджений постановою Кабінету Міністрів України від 28.01.2004 р. № 86 (у редакції постанови Кабінету Міністрів України від 05.04.2012)